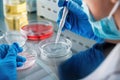

Find results that contain all of your keywords. Content filter is on.
Search will return best illustrations, stock vectors and clipart.
Choose orientation:
Make it so!
You have chosen to exclude "" from your results.
Choose orientation:
Explore cartoons & images using related keywords:
scientist
laboratory
test
tubes
colorful
chemistry
research
experiment male closeup glassware vibrant science education analysis liquid purple yellow blue green orange pink professional concentration innovation technology healthcare academic equipment coat chemical study researcher scientific setup liquids beaker flask observation precision stem environment modern creative focus colors tools close setting generativeClose Up Of Scientist With Colorful Test Tubes In Laboratory Setting Generative AI Royalty-Free Stock Photo
Designed by
Title
Close up of scientist with colorful test tubes in laboratory setting Generative AI #342248187
Description